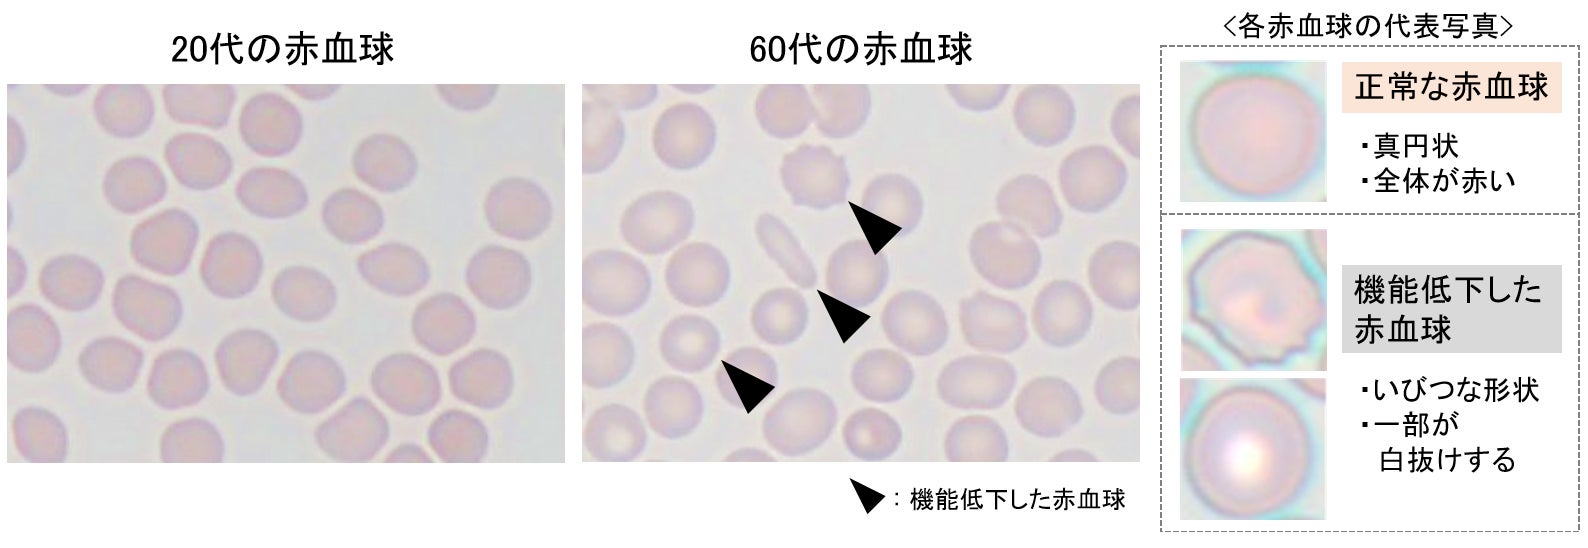

加齢に伴う疲れやすさに赤血球の機能低下が関与することを発見
日本メナード化粧品株式会社(愛知県名古屋市中区丸の内3-18-15、代表取締役社長:野々川 純一)は、加齢に伴い血液中に機能低下した赤血球の割合が増加すること、その結果身体が疲れやすくなっていくことを発見しました。また、機能低下した赤血球が増加する一因として、IL-1αと呼ばれる炎症性物質が関与していることも特定しました。さらに、唾液中のIL-1α量を測定することで赤血球の状態や疲労状態を推定できる可能性を見出しました。これらの研究成果は、今後の抗疲労研究や疲労回復商品の開発への応用が期待されます。
疲労の原因は全身におけるエネルギー産生の低下と考えられており、エネルギー産生に必要な酸素を運搬する赤血球は重要な役割を担っていると考えられていますが、赤血球と疲労との関係については不明な点が多く存在します。
今回、年を取ると疲れやすくなる原因を解明するため、加齢に伴う疲労と赤血球の状態について調査しました。健常人を対象に疲労と赤血球の状態を解析した結果、高齢になるほど機能低下した赤血球の割合が増加すること、機能低下した赤血球の割合が多い人ほど疲労していることが明らかになりました。また、機能低下した赤血球の割合が増加する原因として、IL-1αと呼ばれる炎症性物質が関係していることを突き止めました。さらに、IL-1αは加齢によって増加することも明らかになりました。IL-1αには赤血球を生み出す造血幹細胞の機能を抑制する作用があり、新しい赤血球の産生を妨げるため、IL-1αが増えることで血液中に機能低下した赤血球の割合が増加すると考えられました。
さらに、唾液中と血液中のIL-1α量に相関があることも見出しました。唾液中のIL-1α量を測定することで、赤血球の機能を推定でき、疲労リスクの予測が可能になると考えられます。
今後は本研究成果を、何歳になっても活躍できる社会の実現に向けて、疲労のメカニズム解明や疲れにくい身体を維持するための抗疲労研究に応用していきます。なお、本研究成果の一部は、「Biogerontology」 (オンライン版)に掲載されました。
<参考資料>
1.加齢に伴う赤血球の機能低下と疲労の関係
貧血症状のない健常人(20代~60代男性)を対象に赤血球の状態と疲労の指標を解析しました。
1-1.加齢に伴い機能低下した赤血球の割合が増加する
赤血球は、すべての血液中の細胞のもととなる造血幹細胞と呼ばれる細胞から生み出され、全身に酸素を運搬する働きを担っています。しかし、老化したり活性酸素などによりダメージを受けたりすると、酸素を運搬する機能が低下してしまいます。
若齢群と加齢群の赤血球を比較した結果、若齢群では正常な赤血球が多く存在していたのに対し、加齢群では機能低下した赤血球の割合が大きくなっていました(図1)※1。
※1 赤血球の機能低下は、観察画像から判断できることが報告されている。正常では真円状で全体が赤くなっているのに対し、機能が低下している赤血球はいびつな形状や一部が白抜けするといった特徴がみられる。

1-2.赤血球の機能低下が疲れやすさに関与する
赤血球の機能低下と疲労との関係を解明するため、疲労の指標である自律神経活動量※2と赤血球の機能を解析した結果、機能低下した赤血球の割合が大きいと疲れやすいことがわかりました(図2)。疲労は身体のエネルギー源であるATP産生の低下によって引き起こされます。ATPの産生には酸素が重要であることから、機能低下した赤血球の割合が増えることで酸素の供給が滞り、エネルギー産生が減少し、疲労につながると推察されました。
※2 心拍から算出される自律神経機能の指標のうち、自律神経の全体的な活性を表す自律神経活動量(TP:Total Power)の値を測定し疲労の指標とした。

2.機能低下した赤血球の割合が増加する原因
加齢により機能低下した赤血球の割合が増加する原因を解明するため、赤血球を生み出す造血幹細胞に着目しました。また、近年、加齢に伴い身体に蓄積する老化細胞が炎症性物質などを分泌し、周辺組織にダメージを与えるSASP※3と呼ばれる現象が注目されています。今回、老化細胞が分泌するSASP因子※4が赤血球の産生に影響を及ぼすのではないかと考え、造血幹細胞に対する様々なSASP因子の影響を解析しました。
その結果、SASP因子のひとつであるIL-1αに、造血幹細胞の赤血球への分化を抑制する作用を確認しました(図3A)。つまり、IL-1αによって新しい赤血球が生まれにくくなり、機能低下した赤血球が血液中に留まってしまうことでその割合が増加すると考えられました。さらに、血液中のIL-1α量を測定した結果、年齢との相関が認められました。(図3B)。
※3 Senescence-associated secretory phenotype(細胞老化随伴分泌現象)
※4 SASPにより分泌される物質の総称

3.唾液解析による疲労リスクの予測
赤血球の分化にIL-1αが関与することから、体内のIL-1αの濃度を測定することで赤血球の状態を推定し、疲労リスクを予測できると考えました。しかし、血液の採取は身体への負担が大きいため、採取の負担が少ない唾液によって体内のIL-1αの測定が可能か検討しました。
血中のIL-1α濃度と唾液中に含まれるIL-1α濃度の関連を解析した結果、唾液中のIL-1α濃度が血中のIL-1α濃度を反映していることを確認しました(図4A)。次に、唾液中のIL-1αと赤血球機能との関係を解析した結果、唾液中のIL-1αの濃度が高い人ほど機能低下した赤血球の割合が多いことがわかりました(図4B)。このことから、唾液中のIL-1α濃度を測定することで、赤血球の状態を推定し、疲労リスクを予測することが可能だと考えられました。

4.掲載雑誌・タイトル・著者について
雑誌名: Biogerontology
論文タイトル: Analysis of the relationship between age-related erythrocyte dysfunction and fatigue
掲載アドレス: https://doi.org/10.1007/s10522-024-10106-w
著者: 大形 悠一郎1、藤村 将大1、五十嵐 敏夫1、山田 貴亮1、長谷川 靖司1, 2
所属:
1日本メナード化粧品株式会社 総合研究所
2 名古屋大学大学院 医学系研究科 名古屋大学メナード協同研究講座
このプレスリリースには、メディア関係者向けの情報があります
メディアユーザー登録を行うと、企業担当者の連絡先や、イベント・記者会見の情報など様々な特記情報を閲覧できます。※内容はプレスリリースにより異なります。
すべての画像
- 種類
- その他
- ビジネスカテゴリ
- ダイエット・健康食品・サプリメントフィットネス・ヘルスケア
- ダウンロード